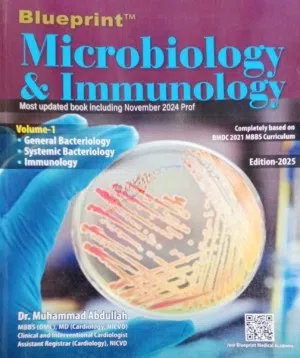

-
Medical Books
- 100 Cases Series
- ABC Series
- AMC
- Anatomy
- Anesthesiology
- At a Glance
- Axis Book Series
- Biochemistry
- Blueprints Series
- Breast and Endocrine Surgery
- BRS Series
- Cardiology
- Cardiovascular & Thoracic Surgery
- Case Files Series
- Clinical Cases Uncovered Series
- Clinical Experience
- Community Medicine
- Critical Care
- Critical Care Medicine
- CURRENT Diagnosis & Treatment Series
- Dermatology
- Nose and Throat (ENT)
- Easy Medical Book Series
- ECG X-RAY & Ultrasound
- Embryology
-
Medical Books
- Emergencies Series
- Emergency Medicine
- Endocrinology & Diabetes
- Endoscopy
- Epidemiology
- Forensic Medicine
- FCPS/MS/Residency/Diploma
- Forensic Medicine
- Fun Series
- Gastroenterology
- General Practice
- General Surgery
- Guidelines
- Genesis Book Series
- Hepatology
- Health Care
- Hearts Series
- Hepatology
- High-Yield Series
- Histology
- Hypertension
- Immunology
- Infectious Diseases
- Internal Medicine
- Laboratory Medicine
-
Medical Books
- Lecture Notes
- Matrix book Series
- Med Student Notes
- Medical Dictionary
- Medical Plus Publication
- Medical Research
- Medicine
- Memorable Series
- Microbiology
- Mnemonics
- MRCP/MRCS/USMLE
- National Guidelines
- Neonatology
- Nephrology
- Neuroanatomy
- Neurology
- Neurosurgery
- Obstetrics & Gynecology
- On Call Series
- Oncology
- Ophthalmology
- Oral and Maxillofacial Surgery
- Oral Medicine
- Orthodontic Treatment
- Orthodontics
-
Medical Books
- Orthopaedics & Trauma
- Otolaryngology
- Oxford Handbook Series
- Oxford Specialist Handbook Series
- Parasitology
- Pathology
- Pediatric Surgery
- Pediatrics
- Pharmacology
- Physical Medicine
- Physiology
- Physiotherapy
- Plastic and Reconstructive Surgery
- Post Graduation
- Psychiatry
- Pulmonology/Respiratory Medicine
- Question Bank
- Radiology and Imaging
- Respiratory Medicine
- Rheumatology
- Secrets Series
- Step Up Series
- Surgery
- Synapse Book Series
- Tuberculosis
- Urology